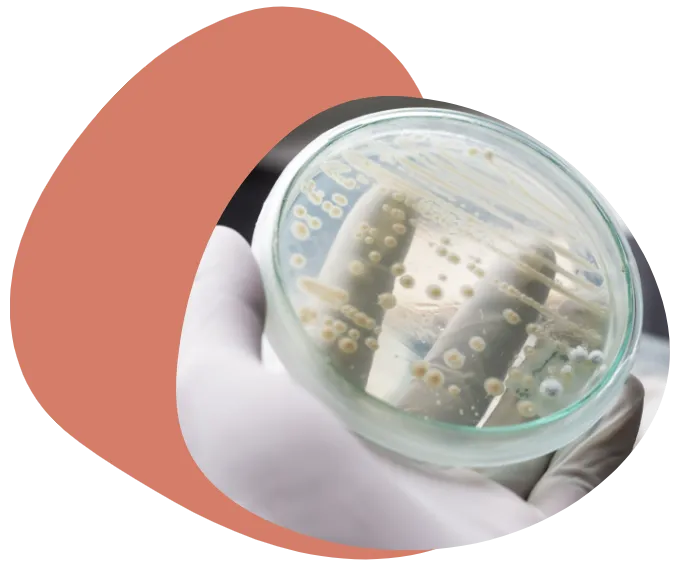

What you get
As we raise the standard for vaginal care, we’re here to listen to anything that’s on your mind, to get you the answers you need and to close the gender health gap with you.
Easy breezy sample collection
Order directly and take the easy vaginal swab in your pyjamas.
Comprehensive testing
We identify all the bacteria present, not just a few.
Personalised report in human speak
Every vagina is unique and we’ll clearly explain what your microbes mean for you.
1:1 Consultation
A vaginal coach will take you through your results.
Invite to the Juno community
We’re here to get you the answers you need.
We've helped 10,000+ people on their vaginal health journeys.

We’re on a mission to close the gender health gap